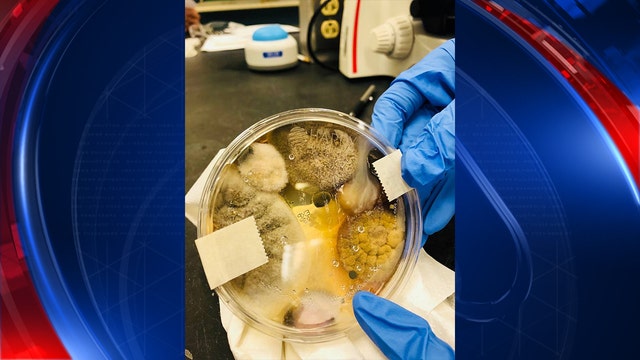
Viral Facebook post sparks fears over how clean bathroom hand dryers are

White House advisers come to defense of President Trump amid aide resignation, tweet
Reeling from the downfall of a senior aide, the White House was on the defensive Sunday, attempting to soften President Donald Trump's comments about the mistreatment of women while rallying around the embattled chief of staff.
Reeling from the downfall of a senior aide, the White House was on the defensive Sunday, attempting to soften President Donald Trump's comments about the mistreatment of women while rallying around the embattled chief of staff.
2 Ohio officers killed in line of duty Saturday; wife of suspect called 911
Police in Ohio had previously gone to the home where a man fatally shot two police officers for three domestic disputes but no arrests were ever made, incident reports from the Columbus suburb of Westerville show.
Police in Ohio had previously gone to the home where a man fatally shot two police officers for three domestic disputes but no arrests were ever made, incident reports from the Columbus suburb of Westerville show.
Cashier pays for Bay Area mom's groceries
A Bay Area mom of two boys was moved to tears when a stranger offered to help pay for her groceries on Friday.
A Bay Area mom of two boys was moved to tears when a stranger offered to help pay for her groceries on Friday.
Increased prices at Disney parks in Florida, California
Ticket prices at Walt Disney World in Orlando and at Disneyland in California are increasing, company officials said Sunday. Starting Sunday, "value" days for Magic Kingdom will cost $109 for adults and $103 for children, which represent a $2 increase. During "regular" time, park visitors will pay $4 more with prices jumping to $119 for adults and $113 for children. The...
Ticket prices at Walt Disney World in Orlando and at Disneyland in California are increasing, company officials said Sunday. Starting Sunday, "value" days for Magic Kingdom will cost $109 for adults and $103 for children, which represent a $2 increase. During "regular" time, park visitors will pay $4 more with prices jumping to $119 for adults and $113 for children. The...
Pentagon receiving $700 billion in new budget bill
It's the biggest budget the Pentagon has ever seen: $700 billion. That's far more in defense spending than America's two nearest competitors, China and Russia, and will mean the military can foot the bill for thousands more troops, more training, more ships and a lot else.
It's the biggest budget the Pentagon has ever seen: $700 billion. That's far more in defense spending than America's two nearest competitors, China and Russia, and will mean the military can foot the bill for thousands more troops, more training, more ships and a lot else.
2 Ohio police officers killed, shot while on call in suburb of Columbus
Two police officers were killed Saturday while responding to a call in Westerville, Ohio, reports say.
Two police officers were killed Saturday while responding to a call in Westerville, Ohio, reports say.
Disgraced former gymnastics doctor sent to Arizona prison
TUCSON, Ariz. (AP) - Prison records show that disgraced former gymnastics doctor Larry Nassar has been transferred to a federal prison in Tucson, Arizona. The Federal Bureau of Prisons online inmate registry on Saturday showed that the 54-year-old was housed at the high security prison that also has an adjacent minimum security satellite camp. Nassar faces two long prison sentences in Michigan...
TUCSON, Ariz. (AP) - Prison records show that disgraced former gymnastics doctor Larry Nassar has been transferred to a federal prison in Tucson, Arizona. The Federal Bureau of Prisons online inmate registry on Saturday showed that the 54-year-old was housed at the high security prison that also has an adjacent minimum security satellite camp. Nassar faces two long prison sentences in Michigan...
Health officials: Third NYC child dies of the flu
NEW YORK (AP) - Health officials say a third child has died of the flu in New York City this winter. The Department of Health and Mental Hygiene reported the fatality on Friday, and urged both parents and children to get vaccinated. No details were immediately released about the latest pediatric flu fatality. The second child, an 8-year-old girl from Queens, died on Monday, and the first last...
NEW YORK (AP) - Health officials say a third child has died of the flu in New York City this winter. The Department of Health and Mental Hygiene reported the fatality on Friday, and urged both parents and children to get vaccinated. No details were immediately released about the latest pediatric flu fatality. The second child, an 8-year-old girl from Queens, died on Monday, and the first last...
You can get the flu more than once per season
The flu can knock you out. But even though you've had the flu this season, you can get it again, according to Dr. Marc Siegel, a professor of medicine at NYU Langone Hospital and a Fox News medical contributor.
The flu can knock you out. But even though you've had the flu this season, you can get it again, according to Dr. Marc Siegel, a professor of medicine at NYU Langone Hospital and a Fox News medical contributor.
Mother & daughter receive special needs van in act of generosity
In a heartwarming update to a story that aired on KTVU last month, a struggling single mother was able to get her 12-year-old daughter, who is in a wheelchair, a special replacement van for their old one that was destroyed in a crash with an uninsured motorist.
In a heartwarming update to a story that aired on KTVU last month, a struggling single mother was able to get her 12-year-old daughter, who is in a wheelchair, a special replacement van for their old one that was destroyed in a crash with an uninsured motorist.
California lawmakers introduce 'Safe Youth Football Act' by setting minimum age for tackle football
Just days after the Super Bowl, two California lawmakers announced a bill to prevent minors from playing organized tackle football before high school.
Just days after the Super Bowl, two California lawmakers announced a bill to prevent minors from playing organized tackle football before high school.
2nd White House staffer resigns after abuse allegations
A second White House staffer has departed the Trump administration in the wake of abuse allegations.
A second White House staffer has departed the Trump administration in the wake of abuse allegations.
Trump won't declassify Democratic memo on Russia probe
Citing national security concerns, the White House on Friday formally notified the House intelligence committee that President Donald Trump is "unable" to declassify a memo drafted by Democrats that counters GOP allegations about abuse of government surveillance powers in the FBI's Russia probe.
Citing national security concerns, the White House on Friday formally notified the House intelligence committee that President Donald Trump is "unable" to declassify a memo drafted by Democrats that counters GOP allegations about abuse of government surveillance powers in the FBI's Russia probe.
Police: Atlanta Hawks player arrested after driving 128 mph
Atlanta Hawks player DeAndre' Bembry has been arrested after speeding on Interstate 85, according to the Atlanta Police Department.
Atlanta Hawks player DeAndre' Bembry has been arrested after speeding on Interstate 85, according to the Atlanta Police Department.
‘Severe winter weather' could bring up to 12 inches of snow by Sunday morning
Drivers are advised to use caution while making their way to work Friday morning as a powerful winter storm that could bring up to 12 inches of total snowfall continues to push through the Chicago area over the weekend.
Drivers are advised to use caution while making their way to work Friday morning as a powerful winter storm that could bring up to 12 inches of total snowfall continues to push through the Chicago area over the weekend.
Viral Facebook post sparks fears over how clean bathroom hand dryers are
A woman's viral Facebook post is sparking concerns over just how clean those hand dryers at public bathrooms actually are.
A woman's viral Facebook post is sparking concerns over just how clean those hand dryers at public bathrooms actually are.
Thieves are targeting cars for their airbags
When you get out of your car, you take your wallet, phone, keys, lock the car, but you're still leaving behind something even more valuable to thieves.
When you get out of your car, you take your wallet, phone, keys, lock the car, but you're still leaving behind something even more valuable to thieves.
Winter storm pounding Midwest blamed for 2 deaths
A winter storm pounding the Midwest caused at least two deaths Friday, authorities said, while closing schools and forcing the cancellation of hundreds of flights.
A winter storm pounding the Midwest caused at least two deaths Friday, authorities said, while closing schools and forcing the cancellation of hundreds of flights.
Driver's licenses could soon be replaced by cell phone apps
Your driver's license could be replaced by a cellphone app if a pilot program involving four states and the District of Columbia works out.
Your driver's license could be replaced by a cellphone app if a pilot program involving four states and the District of Columbia works out.
Winter Haven pastor arrested for child rape
A Polk County church pastor has been arrested for having sex with a minor, announced Polk County deputies Friday morning.
A Polk County church pastor has been arrested for having sex with a minor, announced Polk County deputies Friday morning.